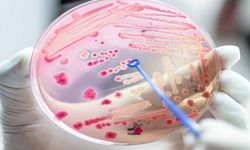
Sepsis Nedir? Nedenleri, Belirtileri ve Tedavisi

Otomotiv dünyasında kullanılan bazı terimler sürücüler için her zaman anlaşılır olmayabilir. Bu terimlerden biri de "rölanti"dir. Rölanti, araçların çalışma sistemlerinde önemli bir rol oynar ve doğru bir şekilde kullanılması gereken bir kavramdır. Her sürücünün rölantiyi anlaması ve gerektiğinde uygulaması, araç bakımı ve güvenliği için kritik öneme sahiptir.
Rölanti Nedir? Ne İşe Yarar?
Rölanti, aracın motorunun çalışmaya devam edebilmesi için gereken en düşük devir hızını ifade eder. Bu devir sayısı, aracın markasına ve modeline bağlı olarak değişiklik gösterebilir. Ancak genel olarak rölanti devir hızı, 500 - 1000 devir/dakika arasında değişir. Aracınızı ilk çalıştırdığınızda, motor rölantide çalışmaya başlar. Rölanti durumunda motor devri düşük olmasına rağmen motor çalışmaya devam eder, fakat gaz pedalına basılmadığı sürece araç ilerlemez.
Rölanti, aracın stop etmesini engeller ve motorun devamlılık sağladığı düşük devirde çalışmasını sağlar. Aracınız debriyaja basıldığı sürece, motorun dönüş hareketi araca iletilmez ve araç hareketsiz kalır. Rölanti durumu, araca zarar vermeden motorun düzgün bir şekilde çalışmasına yardımcı olur ve kontrol tamamen sürücüdedir.
Aracı Rölantide Kullanmak Ne Demektir?
Aracı rölantide kullanmak, motoru çalıştırdıktan sonra aracın hareket etmeye hazır bir durumda bekletilmesidir. Araba minimum çalışma devrindeyken, motorun çalışmaya devam etmesi sağlanır. Aracı harekete geçirmek için, vites değiştirilip gaz pedalına basıldığında motor devri yükselir ve araç hareket etmeye başlar. Özellikle manuel vitesli araçlarda, rölanti sırasında debriyaja da basılması gerekebilir. Bu, motorun devir seviyesini dengeleyerek düzgün bir kalkış yapılmasına yardımcı olur.
Aracı Rölantide Kullanmanın Avantajları ve Dezavantajları
Rölanti sürecinin araç için faydalı mı yoksa zararlı mı olduğu konusu, sürücüler arasında sıkça tartışılan bir konudur. Aslında, rölanti kullanımının faydalı veya zararlı olması, kullanılan süre ve şartlara bağlıdır.
Aracı Rölantide Kullanmanın Faydaları Nelerdir?
Rölanti, özellikle soğuk havalarda motoru ısıtma amacıyla faydalı olabilir. Eski model araçlarda, soğuk havalarda motorun verimli çalışabilmesi için kısa bir süre rölantide bekletmek gerekebilir. Ancak yeni nesil araçlar, soğuk havalardan etkilenmez ve motorun ısınması daha hızlı gerçekleşir. Yine de, aracı çalıştırdıktan sonra 15-30 saniye arasında rölantide beklemek, motorun düzgün bir şekilde çalışmasına yardımcı olur ve daha kontrollü bir kalkış sağlar.
Aracı Rölantide Kullanmanın Zararları Nelerdir?
Uzun süre rölantide beklemek, bazı olumsuz sonuçlar doğurabilir. Birincisi, motor çalıştığı sürece yakıt tüketir. Bu nedenle, aracınızı harekete geçirmeden uzun süre rölantide tutmak, boşuna yakıt tüketmenize yol açar. Ayrıca, çok uzun süre rölantide beklemek motor aksamlarına zarar verebilir. Eğer bir yerde 1-2 dakika kadar beklemeniz gerekiyorsa, aracınızı stop ettirmeniz daha sağlıklı olacaktır. Bu sayede hem yakıt tasarrufu sağlanır hem de motor gereksiz yere ısınmaz.
Rölanti Ayarı Nasıl Yapılır?
Rölanti ayarı, aracın hangi devirde rölantide kalacağını belirleyen bir ayardır. Her araç, fabrikadan çıkarken belirli bir devirde rölantide çalışacak şekilde ayarlanır. Ancak kullanım koşulları, arızalar ve bakım süreçleri bu ayarın bozulmasına yol açabilir. Rölantinin düşük veya yüksek olması, araçta farklı problemlere neden olabilir. Bu gibi durumlar aracın verimli çalışmamasına yol açabileceği gibi, motor parçalarına da zarar verebilir.
Rölanti ayarı, eski model araçlarda genellikle karbüratör üzerindeki bir vida ile yapılır. Dizel motorlu araçlarda ise enjektörlere iletilen yakıt miktarı ile rölanti ayarı yapılır. Günümüzün yeni nesil araçlarında ise rölanti ayarı, sensörler ve motor kontrol ünitesi (ECU) aracılığıyla otomatik olarak yapılır.
Rölanti Dalgalanması Nedir?
Rölanti dalgalanması, aracın motoru boşta çalışırken devirdeki düzensizlikleri ifade eder. Aracın rölanti durumunda, devir saatinde dalgalanma görülmesi, genellikle bir arıza belirtisidir. Bu dalgalanma, motorun rölanti sistemindeki bileşenlerden, yakıt sistemine kadar birçok farklı nedenle ortaya çıkabilir.
Rölanti Motoru Arızası Neden Olur? Nasıl Giderilir?
Rölanti motoru, motorun gaz verilmeden çalışmaya devam etmesini sağlayan bir bileşendir. Bu parça, motorun rölanti devrinde stabil çalışmasını sağlar. Eğer rölanti motoru arızalanırsa, aracınızda çeşitli problemlere yol açabilir. Başlıca belirtiler şunlar olabilir:
-
Motor arıza lambasının yanması
-
Devir saatinde rölanti dalgalanması
-
Aracın rölantideyken stop etmesi
-
Aracın yüksek devire ihtiyaç duyması
-
Aracın normalden fazla yakıt tüketmesi
-
Aracın rölantideyken titreme yapması
Bu tür belirtiler, genellikle rölanti motoru arızasının işaretleridir. Bu durumda, en kısa sürede yetkili servise başvurup aracınızın bakım ve onarımını yaptırmanız gerekmektedir.